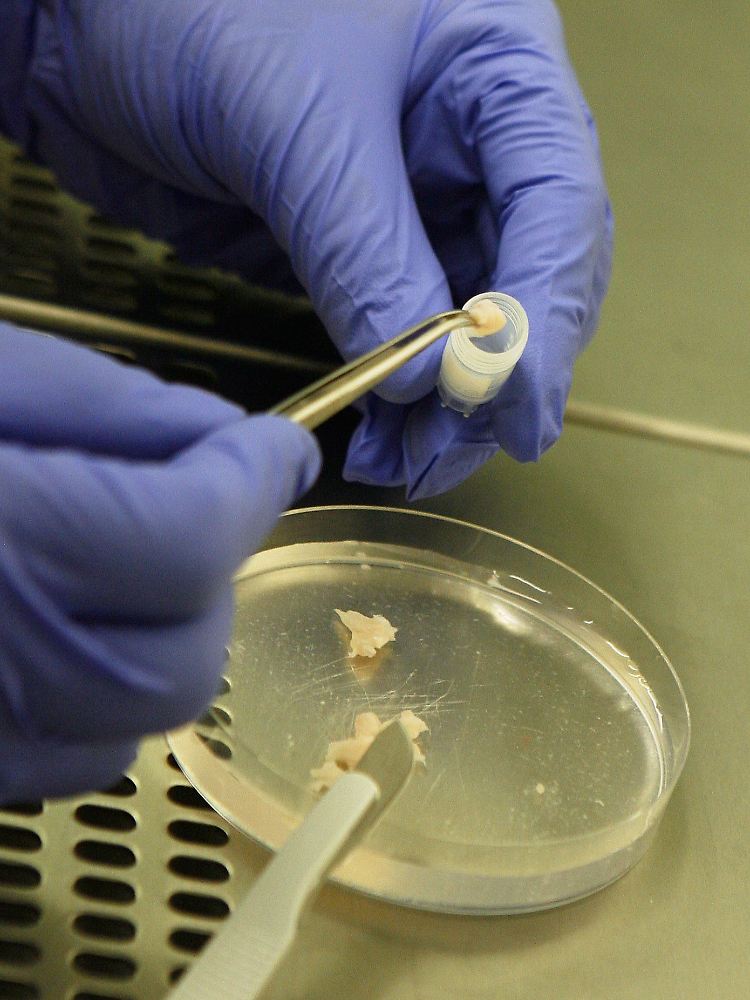

Neue Hoffnung für Kinderlose Gebärmutter von Toten implantiert
06.10.2011, 11:47 Uhr
(Foto: ASSOCIATED PRESS)
Ärzten in der Türkei gelingt die Transplantation einer Gebärmutter. Das Organ stammt von einer Toten und wird von der Empfängerin bisher gut angenommen. Nun hofft die Patientin auf Nachwuchs. Bisher war die Verpflanzung eines Uterus nicht geglückt.
Eine Operation in der Türkei macht tausenden kinderlosen Frauen Hoffnung: Ärzte des Universitäts-Krankenhauses Akdeniz bei Antalya haben der jungen Derya Sert als erster Frau der Welt erfolgreich die Gebärmutter einer verstorbenen Spenderin transplantiert - und fast zwei Monate nach dem Eingriff sieht es so aus, als habe die Empfängerin alles gut überstanden. Nun hoffen die 21-Jährige, die ohne Uterus geboren wurde, und ihr Mann auf Nachwuchs. "Ich bin froh und aufgeregt, alles auf einmal", sagt Sert. "Wenn Gott will, dann halten wir bald unser Baby in den Armen."
Nur eine von 5000 Frauen wird ohne Gebärmutter geboren. Bei der zuvor einzigen Gebärmuttertransplantation in Saudi-Arabien hatten Ärzte im Jahr 2000 den Uterus einer lebenden Spenderin entnommen. Doch der Körper der Patientin stieß das Organ ab, nach 99 Tagen musste es wieder entfernt werden.
Aus Fehlern lernen
In Belgien wurde weltweit die erste erfolgreiche Transplantation von Eierstockgewebe bei Zwillingsschwestern vorgenommen.
(Foto: picture-alliance/ dpa)
"Mit einer lebenden Spenderin war es damals schwieriger", betont der Chirurg Ömer Özkan, der am 9. August zum 15-köpfigen Team der Operation im türkischen Akdeniz bei Antalya zählte. Die Gynäkologin Münire Erman Akar war ebenfalls mit von der Partie. Sie schätzt, bei dem Eingriff im Jahr 2000 hätten die Ärzte in Saudi-Arabien der Spenderin nicht ausreichend Blutgefäße entnehmen können, um ein Anwachsen des Uterus im Körper der Patientin zu ermöglichen.
Aus solchen Problemen wollen die türkischen Mediziner gelernt haben. Weil sie das Organ einer Toten entnehmen konnten, konnten sie mehr Gewebe übertragen. Und inzwischen gibt es nach ihren Angaben Medikamente, die Abwehrreaktionen des Immunsystems gegen ein Spenderorgan wirksamer bekämpfen.
Organ im Körper angekommen
"Die Operation ist gut verlaufen", sagt Chirurg Özkan sachlich. Die Ärzte seien froh, dass sich das Organ nicht abgestoßen wurde. Die Patientin hat bereits ihre Periode bekommen, ein Zeichen für die Integration des Organs in den Körper. Doch Özkan gibt sich zurückhaltend: "Man kann erst von einem Erfolg sprechen, wenn sie ihr Kind bekommt."
Nur wenige Mediziner beschäftigen sich mit Uterus-Transplantationen; neben der Türkei wird nur in Schweden und in den USA daran geforscht. "Ich hatte niemals Angst vor der Operation", beteuert Derya Sert. Sie hatte vor gut einem Jahr von der Möglichkeit einer Transplantation erfahren, und auch, dass ein solcher Eingriff noch nie geglückt war. "Ich habe nie an die Schmerzen gedacht, die man dabei hat."
Hoffnung auf ein eigenes Kind
Mindestens sechs Monate sollen Derya Sert und ihr Mann, ein Mechaniker, warten - dann könnten Ärzte versuchen, ihr vor der Transplantation entnommene, mit dem Sperma ihres Mannes befruchtete Eizellen einzusetzen. Eine Schwangerschaft wäre dann möglich, aber mit Unwägbarkeiten behaftet, erläutert Gynäkologin Akar: Die Medikamente, die Sert nehmen muss, damit das fremde Organ nicht abgestoßen wird, könnten zu Missbildungen am Embryo führen. Auch die Wehen könnten zu früh einsetzen oder der Embyro könnte zu langsam wachsen. Um der Gesundheit des Ungeborenen willen müssten die Medikamentengaben nach und nach reduziert werden.
Und nach einer Schwangerschaft würde die Gynäkologin am liebsten den transplantierten Uterus gleich wieder entfernen, um ein Abstoßen zu verhindern. Darüber entscheiden müsste aber natürlich die Patientin, sagt Akar. Alle diese Sorgen kümmern Derya Sert derzeit nicht. Auf ihrem Klinikbett strahlt die Patientin. "Ich wäre glücklich, wenn ich Frauen in derselben Situation Hoffnung geben könnte", sagt die 21-Jährige. "Ich wünsche mir, dass sie ihren Traum verwirklichen können."
Quelle: ntv.de, Safak Timur, AFP